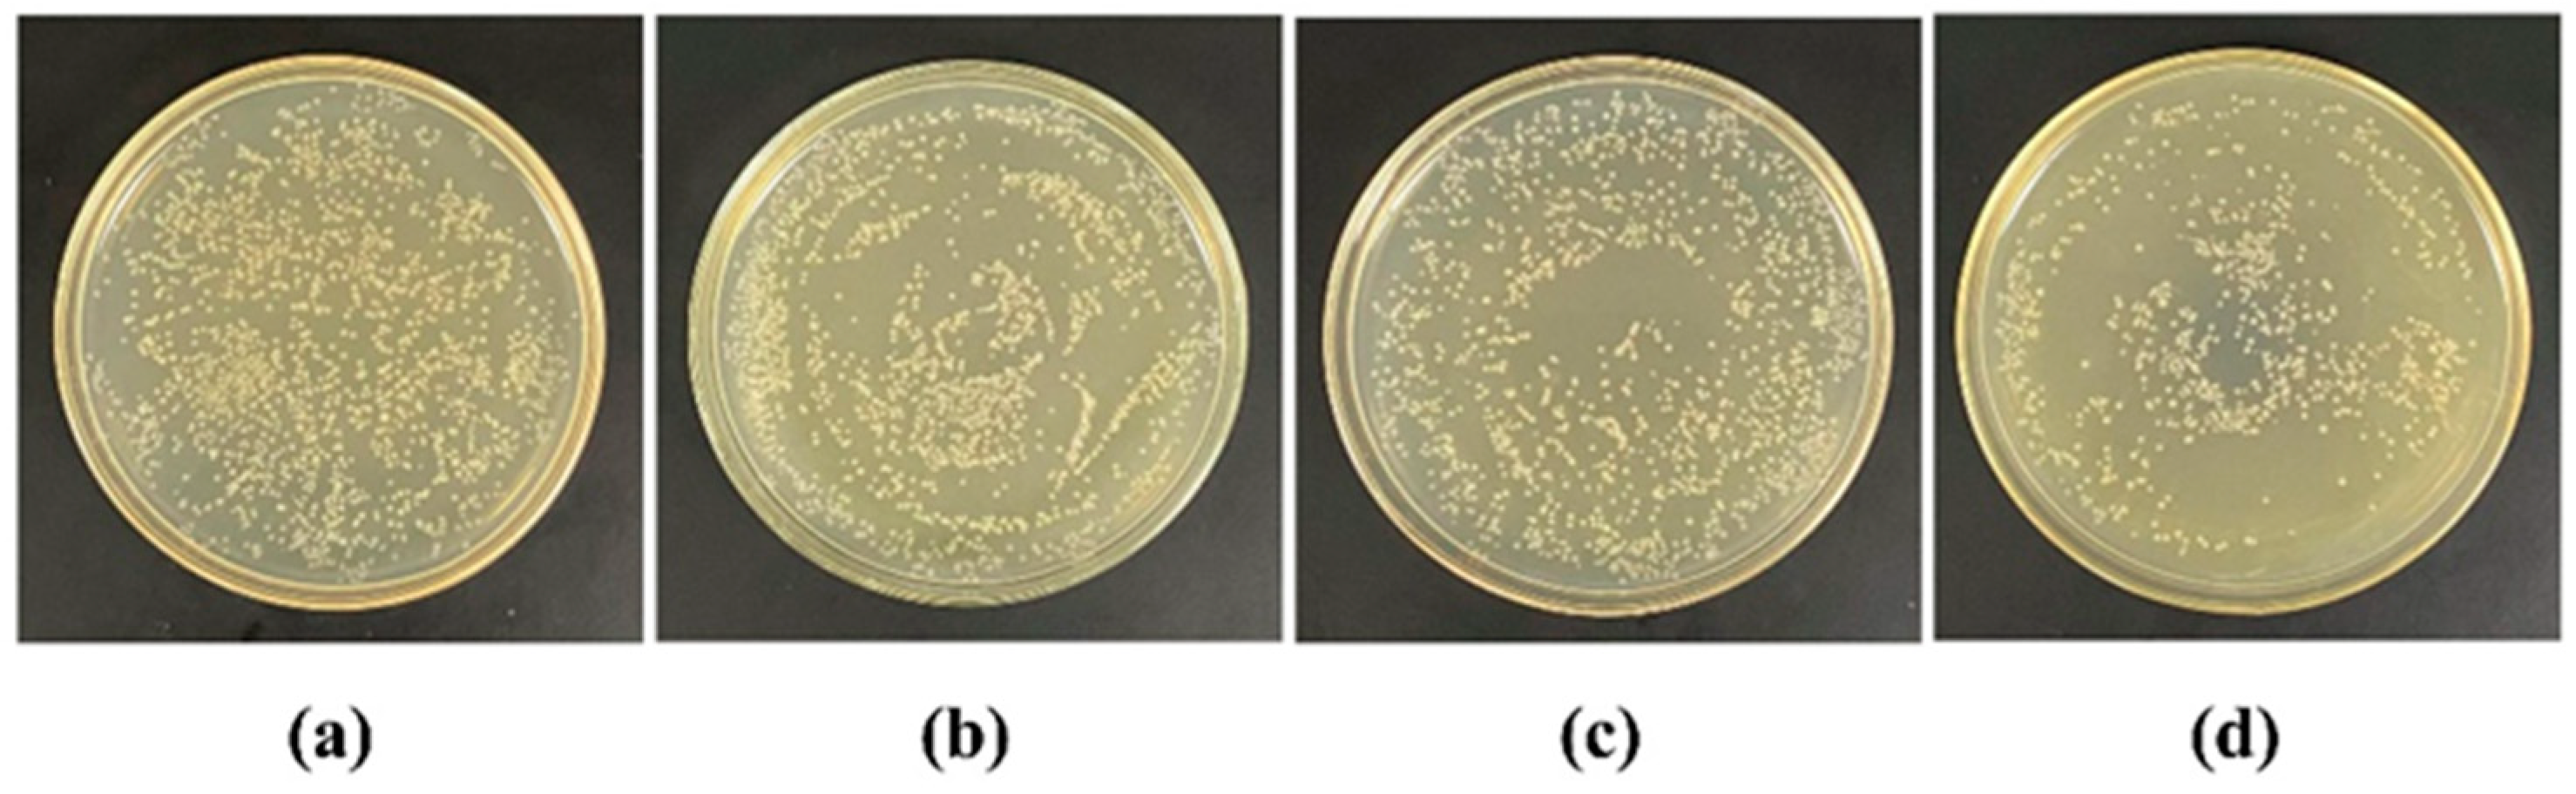

UV-Triggered Drug Release from Mesoporous Titanium Nanoparticles Loaded with Berberine Hydrochloride: Enhanced Antibacterial Activity
Abstract
1. Introduction
2. Results and Discussion
2.1. Preparation and Characterization of MTN, MTN-PEI, and BH@MTN-PEI
2.2. In Vitro Release Evaluation
2.3. Antibacterial Study
3. Materials and Methods
3.1. Materials
3.2. Methods
3.2.1. Preparation of MTN
3.2.2. Preparation of MTN-PEI
3.3. Characterization
3.4. Preparation of BH-Loaded MTN-PEI
3.5. UV-Controlled Drug Release Experiments
3.6. Bioactivity Studies of Antibacterial Nanoplatforms In Vitro
4. Conclusions
Supplementary Materials
Author Contributions
Funding
Data Availability Statement
Conflicts of Interest
References
- Sun, H.; Sun, M.Y.; You, Y.H.; Xie, J.; Xu, X.Y.; Li, J.S. Recent progress of intelligent antibacterial nanoplatforms for treating bacterial infection. Chem. Eng. J. 2023, 471, 144597. [Google Scholar] [CrossRef]
- Wang, Z.; Liu, X.Y.; Duan, Y.W.; Huang, Y. Infection microenvironment-related antibacterial nanotherapeutic strategies. Biomaterials 2022, 280, 121249. [Google Scholar] [CrossRef] [PubMed]
- Lia, S.J.; Zhang, Y.P.; Pan, X.H.; Zhu, F.Z.; Jiang, C.Y.; Liu, Q.Q.; Cheng, Z.Y.; Dai, G.; Wu, G.J.; Wang, L.Q.; et al. Antibacterial activity and mechanism of silver nanoparticles against multidrug-resistant Pseudomonas aeruginosa. Int. J. Nanomed. 2019, 14, 1469–1487. [Google Scholar] [CrossRef] [PubMed]
- Santos, K.S.; Barbosa, A.M.; da Costa, L.P.; Pinheiro, M.S.; Oliveira, M.; Padilha, F.F. Silver Nanocomposite Biosynthesis: Antibacterial Activity against Multidrug-Resistant Strains of Pseudomonas aeruginosa and Acinetobacter baumannii. Molecules 2016, 21, 1255. [Google Scholar] [CrossRef]
- von Baum, H.; Marre, R. Antimicrobial resistance of Escherichia coli and therapeutic implications. Int. J. Med. Microbiol. 2005, 295, 503–511. [Google Scholar] [CrossRef] [PubMed]
- Li, M.C.; Liu, Q.L.; Teng, Y.L.; Ou, L.Y.; Xi, Y.L.; Chen, S.Y.; Duan, G.C. The resistance mechanism of Escherichia coli induced by ampicillin in laboratory. Infect. Drug Resist. 2019, 12, 2853–2863. [Google Scholar] [CrossRef]
- Miklasinska-Majdanik, M. Mechanisms of Resistance to Macrolide Antibiotics among Staphylococcus aureus. Antibiotics 2021, 10, 1406. [Google Scholar] [CrossRef]
- Li, G.; Walker, M.J.; De Oliveira, D.M.P. Vancomycin Resistance in Enterococcus and Staphylococcus aureus. Microorganisms 2023, 11, 24. [Google Scholar] [CrossRef]
- Janda, J.M.; Abbott, L.S. The Changing Face of the Family Enterobacteriaceae (Order: “Enterobacterales”): New Members, Taxonomic Issues, Geographic Expansion, and New Diseases and Disease. Clin. Microbiol. Rev. 2021, 34, 1–45. [Google Scholar] [CrossRef]
- Gomes, T.A.; Elias, W.P.; Scaletsky, I.C.; Guth, B.E.; Rodrigues, J.F.; Piazza, R.M.; Ferreira, L.C.; Martinez, M.B. Diarrheagenic Escherichia coli. Braz. J. Microbiol. 2016, 47 (Suppl. S1), 3–30. [Google Scholar] [CrossRef]
- Mellata, M. Human and avian extraintestinal pathogenic Escherichia coli: Infections, zoonotic risks, and antibiotic resistance trends. Foodborne Pathog. Dis. 2013, 10, 916–932. [Google Scholar] [CrossRef] [PubMed]
- Terlizzi, M.E.; Gribaudo, G.; Maffei, M.E. UroPathogenic Escherichia coli (UPEC) Infections: Virulence Factors, Bladder Responses, Antibiotic, and Non-antibiotic Antimicrobial Strategies. Front. Microbiol. 2017, 8, 1566. [Google Scholar] [CrossRef] [PubMed]
- Arshi, N.; Ahmed, F.; Kumar, S.; Anwar, M.S.; Lu, J.; Koo, B.H.; Lee, C.G. Microwave assisted synthesis of gold nanoparticles and their antibacterial activity against Escherichia coli (E. coli). Curr. Appl. Phys. 2011, 11, S360–S363. [Google Scholar] [CrossRef]
- Fernandes, M.M.; Ivanova, K.; Francesko, A.; Rivera, D.; Torrent-Burgués, J.; Gedanken, A.; Mendonza, E.; Tzanov, T. Escherichia coli and Pseudomonas aeruginosa eradication by nano-penicillin G. Nanomed. Nanotechnol. Biol. Med. 2016, 12, 2061–2069. [Google Scholar] [CrossRef] [PubMed]
- Chen, Y.; Deng, Y.; Pu, Y.; Tang, B.; Su, Y.; Tang, J. One pot preparation of silver nanoparticles decorated TiO2 mesoporous microspheres with enhanced antibacterial activity. Mater. Sci. Eng. C Mater. Biol. Appl. 2016, 65, 27–32. [Google Scholar] [CrossRef]
- Wu, Y.; Zang, Y.; Xu, L.; Wang, J.; Jia, H.; Miao, F. Synthesis of high-performance conjugated microporous polymer/TiO2 photocatalytic antibacterial nanocomposites. Mater. Sci. Eng. C Mater. Biol. Appl. 2021, 126, 112121. [Google Scholar] [CrossRef] [PubMed]
- Ansari, M.A.; Asiri, S.M.M. Green synthesis, antimicrobial, antibiofilm and antitumor activities of superparamagnetic γ-Fe2O3 NPs and their molecular docking study with cell wall mannoproteins and peptidoglycan. Int. J. Biol. Macromol. 2021, 171, 44–58. [Google Scholar] [CrossRef]
- Ferreira, M.; Ogren, M.; Dias, J.N.R.; Silva, M.; Gil, S.; Tavares, L.; Aires-da-Silva, F.; Gaspar, M.M.; Aguiar, S.I. Liposomes as Antibiotic Delivery Systems: A Promising Nanotechnological Strategy against Antimicrobial Resistance. Molecules 2021, 26, 2047. [Google Scholar] [CrossRef] [PubMed]
- Zong, T.X.; Silveira, A.P.; Morais, J.A.V.; Sampaio, M.C.; Muehlmann, L.A.; Zhang, J.; Jiang, C.S.; Liu, S.K. Recent Advances in Antimicrobial Nano-Drug Delivery Systems. Nanomaterials 2022, 12, 1855. [Google Scholar] [CrossRef]
- Gonzalez Gomez, A.; Hosseinidoust, Z. Liposomes for Antibiotic Encapsulation and Delivery. ACS Infect. Dis. 2020, 6, 896–908. [Google Scholar] [CrossRef]
- Zhao, S.; Xia, Y.; Lan, Q.; Wu, Q.; Feng, X.; Liu, Y. pH-Responsive Nanogel for Photothemal-Enhanced Chemodynamic Antibacterial Therapy. ACS Appl. Nano Mater. 2023, 6, 8643–8654. [Google Scholar] [CrossRef]
- Zu, G.; Steinmuller, M.; Keskin, D.; van der Mei, H.C.; Mergel, O.; van Rijn, P. Antimicrobial Nanogels with Nanoinjection Capabilities for Delivery of the Hydrophobic Antibacterial Agent Triclosan. ACS Appl. Polym. Mater. 2020, 2, 5779–5789. [Google Scholar] [CrossRef] [PubMed]
- Barros, C.H.N.; Hiebner, D.W.; Fulaz, S.; Vitale, S.; Quinn, L.; Casey, E. Synthesis and self-assembly of curcumin-modified amphiphilic polymeric micelles with antibacterial activity. J. Nanobiotechnol. 2021, 19, 104. [Google Scholar] [CrossRef] [PubMed]
- Wang, T.; Rong, F.; Tang, Y.; Li, M.; Feng, T.; Zhou, Q.; Li, P.; Huang, W. Targeted polymer-based antibiotic delivery system: A promising option for treating bacterial infections via macromolecular approaches. Prog. Polym. Sci. 2021, 116, 101389. [Google Scholar] [CrossRef]
- Kaushik, M.; Sarkar, N.; Singh, A.; Kumar, P. Nanomaterials to address the genesis of antibiotic resistance in Escherichia coli. Front. Cell Infect. Microbiol. 2022, 12, 946184. [Google Scholar] [CrossRef]
- Schutte-Smith, M.; Erasmus, E.; Mogale, R.; Marogoa, N.; Jayiya, A.; Visser, H.G. Using visible light to activate antiviral and antimicrobial properties of TiO2 nanoparticles in paints and coatings: Focus on new developments for frequent-touch surfaces in hospitals. J. Coat. Technol. Res. 2023, 20, 789–817. [Google Scholar] [CrossRef] [PubMed]
- Ouerghi, O.; Geesi, M.H.; Ibnouf, E.O.; Ansari, M.J.; Alam, P.; Elsanousi, A.; Kaiba, A.; Riadi, Y. Sol-gel synthesized rutile TiO2 nanoparticles loaded with cardamom essential oil: Enhanced antibacterial activity. J. Drug Deliv. Sci. Technol. 2021, 64, 102581. [Google Scholar] [CrossRef]
- Chan, C.M.N.; Ng, A.M.C.; Fung, M.K.; Cheng, H.S.; Guo, M.Y.; Djurišić, A.B.; Leung, F.C.C.; Chan, W.K. Antibacterial and photocatalytic activities of TiO2 nanotubes. J. Exp. Nanosci. 2013, 8, 859–867. [Google Scholar] [CrossRef]
- Adams, L.K.; Lyon, D.Y.; Alvarez, P.J. Comparative eco-toxicity of nanoscale TiO2, SiO2, and ZnO water suspensions. Water Res. 2006, 40, 3527–3532. [Google Scholar]
- Xu, J.; Liu, N.; Wu, D.; Gao, Z.; Song, Y.Y.; Schmuki, P. Upconversion Nanoparticle-Assisted Payload Delivery from TiO2 under Near-Infrared Light Irradiation for Bacterial Inactivation. ACS Nano 2020, 14, 337–346. [Google Scholar] [CrossRef]
- Qin, Y.Y.; Wang, X.Y.; Qiu, P.Y.; Tian, J. Enhanced Photocatalytic Antibacterial Properties of TiO2 Nanospheres with Rutile/Anatase Heterophase Junctions and the Archival Paper Protection Application. Nanomaterials 2021, 11, 2585. [Google Scholar] [CrossRef] [PubMed]
- Chen, Y.; Tang, X.; Gao, X.; Zhang, B.; Luo, Y.; Yao, X. Antimicrobial property and photocatalytic antibacterial mechanism of the TiO2-doped SiO2 hybrid materials under ultraviolet-light irradiation and visible-light irradiation. Ceram. Int. 2019, 45, 15505–15513. [Google Scholar] [CrossRef]
- Bandyopadhyay, S.; Patra, P.H.; Mahanti, A.; Mondal, D.K.; Dandapat, P.; Bandyopadhyay, S.; Samanta, I.; Lodh, C.; Bera, A.K.; Bhattacharyya, D.; et al. Potential antibacterial activity of berberine against multi drug resistant enterovirulent Escherichia coli isolated from yaks (Poephagus grunniens) with haemorrhagic diarrhoea. Asian Pac. J. Trop. Med. 2013, 6, 315–319. [Google Scholar] [CrossRef] [PubMed]
- Du, G.F.; Le, Y.J.; Sun, X.; Yang, X.Y.; He, Q.Y. Proteomic investigation into the action mechanism of berberine against Streptococcus pyogenes. J. Proteom. 2020, 215, 103666. [Google Scholar] [CrossRef] [PubMed]
- Imenshahidi, M.; Hosseinzadeh, H. Berberine and barberry (Berberis vulgaris): A clinical review. Phytother. Res. 2019, 33, 504–523. [Google Scholar] [CrossRef]
- Li, Y.J.; Hu, X.B.; Lu, X.L.; Liao, D.H.; Tang, T.T.; Wu, J.Y.; Xiang, D.X. Nanoemulsion-based delivery system for enhanced oral bioavailability and CaCO2 cell monolayers permeability of berberine hydrochloride. Drug Deliv. 2017, 24, 1868–1873. [Google Scholar] [CrossRef]
- Nguyen, T.X.; Huang, L.; Liu, L.; Abdalla, A.M.E.; Gauthier, M.; Yang, G. Chitosan-coated nano-liposomes for the oral delivery of berberine hydrochloride. J. Mater. Chem. B 2014, 2, 7149–7159. [Google Scholar] [CrossRef]
- Jiang, H.; Wang, T.; Wang, L.; Sun, C.; Jiang, T.; Cheng, G.; Wang, S. Development of an amorphous mesoporous TiO2 nanosphere as a novel carrier for poorly water-soluble drugs: Effect of different crystal forms of TiO2 carriers on drug loading and release behaviors. Microporous Mesoporous Mater. 2012, 153, 124–130. [Google Scholar] [CrossRef]
- Hoang, V.V.; Zung, H.; Trong, N.H.B. Structural properties of amorphous TiO2 nanoparticles. Eur. Phys. J. D 2007, 44, 515–524. [Google Scholar] [CrossRef]
- Sun, S.D.; Song, P.; Cui, J.; Liang, S.H. Amorphous TiO2 nanostructures: Synthesis, fundamental properties and photocatalytic applications. Catal. Sci. Technol. 2019, 9, 4198–4215. [Google Scholar] [CrossRef]
- Ye, M.; Zhang, Q.; Hu, Y.; Ge, J.; Lu, Z.; He, L.; Chen, Z.; Yin, Y. Magnetically Recoverable Core–Shell Nanocomposites with Enhanced Photocatalytic Activity. Chem. Eur. J. 2010, 16, 6243–6250. [Google Scholar] [CrossRef] [PubMed]
- Mai, Z.; Chen, J.; Cao, Q.; Hu, Y.; Dong, X.; Zhang, H.; Huang, W.; Zhou, W. Rational design of hollow mesoporous titania nanoparticles loaded with curcumin for UV-controlled release and targeted drug delivery. Nanotechnology 2021, 32, 205604. [Google Scholar] [CrossRef] [PubMed]
- Zhang, Y.; Cui, Y.L.; Gao, L.N.; Jiang, H.L. Effects of beta-cyclodextrin on the intestinal absorption of berberine hydrochloride, a P-glycoprotein substrate. Int. J. Biol. Macromol. 2013, 59, 363–371. [Google Scholar] [CrossRef] [PubMed]
- Cheng, L.; Xu, P.H.; Shen, B.D.; Shen, G.; Li, J.J.; Qiu, L.; Liu, C.Y.; Yuan, H.L.; Han, J. Improve bile duct-targeted drug delivery and therapeutic efficacy for cholangiocarcinoma by cucurbitacin B loaded phospholipid complex modified with berberine hydrochloride. Int. J. Pharm. 2015, 489, 148–157. [Google Scholar] [CrossRef] [PubMed]
- Xian Zeng, W.Y. Fang Xiang Song, Hong Xia Wang, Yan Li, Preparation of functionalized redox response type TiO2 & mSiO2 nanomaterials and research on anti-tumor performance. J. Drug Deliv. Sci. Technol. 2022, 68, 103120. [Google Scholar]
- Arora, P.; Fermah, A.; Rajput, J.K.; Singh, H.; Badhan, J. Efficient solar light-driven degradation of Congo red with novel Cu-loaded Fe3O4@TiO2 nanoparticles. Environ. Sci. Pollut. Res. Int. 2017, 24, 19546–19560. [Google Scholar] [CrossRef] [PubMed]
- Martín, A.; Morales, V.; Ortiz-Bustos, J.; Pérez-Garnes, M.; Bautista, L.F.; García-Muñoz, R.A.; Sanz, R. Modelling the adsorption and controlled release of drugs from the pure and amino surface-functionalized mesoporous silica hosts. Microporous Mesoporous Mater. 2018, 262, 23–34. [Google Scholar] [CrossRef]
- Wang, T.Y.; Jiang, H.T.; Wan, L.; Zhao, Q.F.; Jiang, T.Y.; Wang, B.; Wang, S.L. Potential application of functional porous TiO2 nanoparticles in light-controlled drug release and targeted drug delivery. Acta Biomater. 2015, 13, 354–363. [Google Scholar] [CrossRef] [PubMed]
- Yadav, H.M.; Kim, J.-S.; Pawar, S.H. Developments in photocatalytic antibacterial activity of nano TiO2: A review. Korean J. Chem. Eng. 2016, 33, 1989–1998. [Google Scholar] [CrossRef]
- Vargas, M.A.; Rodriguez-Paez, J.E. Amorphous TiO2 nanoparticles: Synthesis and antibacterial capacity. J. Non-Cryst. Solids 2017, 459, 192–205. [Google Scholar] [CrossRef]
- Wang, C.Y.; Lou, X.Y.; Cai, Z.; Zhang, M.Z.; Jia, C.; Qin, J.C.; Yang, Y.W. Supramolecular Nanoplatform Based on Mesoporous Silica Nanocarriers and Pillararene Nanogates for Fungus Control. ACS Appl. Mater. Interfaces 2021, 13, 32295–32306. [Google Scholar] [CrossRef]
- Chai, Y.-S.; Lee, J.-C.; Kim, B.-W. Photocatalytic disinfection of E. coli in a suspended TiO2-UV reactor. Koreans Chem. Eng. 2000, 17, 633–637. [Google Scholar] [CrossRef]
- Xu, J.W.; Zhou, X.M.; Gao, Z.D.; Song, Y.Y.; Schmuki, P. Visible-Light-Triggered Drug Release from TiO2 Nanotube Arrays: A Controllable Antibacterial Platform. Angew. Chem.-Int. Ed. 2016, 55, 593–597. [Google Scholar] [CrossRef]
- Hong, H.; Lee, S.; Kim, T.; Chung, M.; Choi, C. Surface modification of the polyethyleneimine layer on silicone oxide film via UV radiation. Appl. Surf. Sci. 2009, 255, 6103–6106. [Google Scholar] [CrossRef]
- Jia, T.; Zhang, J.; Wu, J.; Wang, D.L.; Liu, Q.Z.; Qi, Y.F.; Hu, B.; He, P.; Pan, W.G.; Qi, X.M. Synthesis amorphous TiO2 with oxygen vacancy as carriers transport channels for enhancing photocatalytic activity. Mater. Lett. 2020, 265. [Google Scholar] [CrossRef]

Disclaimer/Publisher’s Note: The statements, opinions and data contained in all publications are solely those of the individual author(s) and contributor(s) and not of MDPI and/or the editor(s). MDPI and/or the editor(s) disclaim responsibility for any injury to people or property resulting from any ideas, methods, instructions or products referred to in the content. |
© 2024 by the authors. Licensee MDPI, Basel, Switzerland. This article is an open access article distributed under the terms and conditions of the Creative Commons Attribution (CC BY) license (https://creativecommons.org/licenses/by/4.0/).
Share and Cite
Zuo, F.; Wang, B.; Wang, L.; He, J.; Qiu, X. UV-Triggered Drug Release from Mesoporous Titanium Nanoparticles Loaded with Berberine Hydrochloride: Enhanced Antibacterial Activity. Molecules 2024, 29, 1607. https://doi.org/10.3390/molecules29071607
Zuo F, Wang B, Wang L, He J, Qiu X. UV-Triggered Drug Release from Mesoporous Titanium Nanoparticles Loaded with Berberine Hydrochloride: Enhanced Antibacterial Activity. Molecules. 2024; 29(7):1607. https://doi.org/10.3390/molecules29071607
Chicago/Turabian StyleZuo, Fanjiao, Boyao Wang, Lizhi Wang, Jun He, and Xilong Qiu. 2024. "UV-Triggered Drug Release from Mesoporous Titanium Nanoparticles Loaded with Berberine Hydrochloride: Enhanced Antibacterial Activity" Molecules 29, no. 7: 1607. https://doi.org/10.3390/molecules29071607
APA StyleZuo, F., Wang, B., Wang, L., He, J., & Qiu, X. (2024). UV-Triggered Drug Release from Mesoporous Titanium Nanoparticles Loaded with Berberine Hydrochloride: Enhanced Antibacterial Activity. Molecules, 29(7), 1607. https://doi.org/10.3390/molecules29071607

